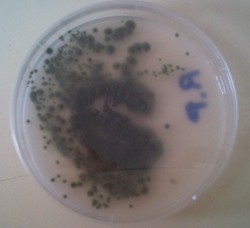

Enfermedades fúngicas:
El repilo y la verticilosis del olivo.
____Las
enfermedades y plagas pueden ocasionar daños al cultivo, la calidad de
las aceitunas o del aceite. Las plagas pueden ser producidas por organismos
superiores, mientras que las enfermedades son causadas por microorganismos (bacterias,
hongos y virus) o debidas a carencias.
____Los hongos son responsables
de algunas enfermedades del olivo. Entre estas el repilo y la verticilosis son
de las más conocidas y que mayores daños ocasionan a este cultivo,
por esta razón las hemos seleccionado para nuestras experiencias. Como
es probable que el trabajo se realice por dos equipos diferentes dividiremos
la página en dos apartados: Repilo y Verticilosis.
OBJETIVOS:
- Profundizar en el conocimiento de estas enfermedades.
- Aprender las técnicas necesarias para el cultivo de
hongos.
- Aprender las técnicas necesarias para la observación
de hongos.
DESARROLLO:
Repilo
____Es una enfermedad
producida por el hongo Cycloconium oleaginum (=Spilocaea oleaginea).
Uno de los síntomas más característicos de esta enfermedad
son manchas circulares en las hojas, inicialmente de color gris o negro. Posteriormente
las hojas atacadas se van poniendo amarillentas y se caen.
- Buscamos información sobre el control de plagas,
informándonos sobre cuales eran las enfermedades del olivo producidas
por microbios, y como se pueden evitar.
- La enfermedad que hemos escogido como tema a desarrollar,
entender y estudiar es el repilo, que es una enfermedad producida por un hongo
llamado Cycloconium oleaginum.
- El siguiente paso que hemos dado es buscar toda la información
posible sobre este hongo y fotos que nos han ayudado a reconocerlo cuando
fuimos a tomar una muestra al campo.
- La muestra que contenía este hongo la guardamos en
una bolsa para estudiarla en el laboratorio
- A partir de esta muestra prepararemos cultivos en placa
y realizaremos observaciones.
- Desde este enlace podremos ver el trabajo final con todos
los detalles cuando esté listo.
Verticilosis
La verticilosis
es una enfermedad causada por el hongo Verticillium dahliae. Tapona los vasos
conductores por lo que los brotes y ramas del olivo se marchitan. Las hojas
no caen, se doblan hacia dentro y las ramas mueren. El hongo se encuentra en
el suelo y penetra en la raíz del árbol donde empieza a desarrollarse.
Vamos a dividir esta página en dos apartados: Investigaciones
previas y Adaptación para la actividad del
stand.
Investigaciones previas.
_____En la siguiente
tabla iremos añadiendo nuestras aportaciones y las imágenes que
vayamos obteniendo junto con los comentarios correspondientes.
_____Desde
aquí podremos acceder a las imágenes y documentos elaborados sobre
el repilo
y la verticilosis.
| Repilo
|
| De momento hemos consultado esta bibliografía que hemos
resumido en un texto sobre la información
del repilo: |
|
| r1 |
|
| r2 |
|
| r3 |
|
| |
|
| |
|
PREPARACIÓN DEL AGAR DE PATATAS
Materiales necesarios:
- Olla de 500ml
- Nevera
- Tubos de ensayo
- Pipeta
- Probeta
- Matraz Erlen Meyer
- Peso
- Calentador
- Mechero a gas
- Placas de Petri
- Alcohol 96º
- Patatas
|
|
Proceso:
Para preparar el agar de patatas, primero cocimos tres patatas, ya peladas,
de tamaño mediano. Una vez cocidas desinfectamos tres botes para
echar los medios preparados.
Preparamos tres medios distintos:
- El primero no era más que el agua de haber cocido las patatas,
que contenía también suero.
- El segundo, patata estrujada para sacarle toda el agua del interior
y hacer un medio más denso.
- El tercero era una mezcla de las dos primeras. Cogimos aproximadamente
200g de patata estrujada y le añadimos 100ml del agua de haberlas
cocido, para obtener una tercera mezcla intermedia.
- Una vez preparadas y en los botes, lo dejamos enfriar una noche en
la nevera.
|
|
A la mañana siguiente fuimos al laboratorio a preparar
el agar.
- Primero desinfectamos el medio, las manos y los utensilios que íbamos
a utilizar.
- Cogimos el primer medio (agua de haber cocido la patata) y medimos
100ml en el tubo de ensayo.
- Lo metimos en el matraz y le añadimos 2g de agar y 1.7g de
glucosa (medidos con un peso), tal y como nos indicaba la receta que
nos dieron en el instituto de la grasa.
|
|
|
- Lo mezclamos bien mientras lo calentábamos, hasta que hirvió.
|
|
Repetimos el proceso con los otros dos medios.
- Al segundo (patata solo) le añadimos 1g de agar y 0.7 de glucosa
(a 100ml del líquido), y la llamamos ‘’P-repilo’’.
- A la tercera preparación (patata y agua de haberla cocido)
le añadimos 1.5g de agar y 1.3g Glucosa (también a 100ml)
y la llamamos ‘’PL-repilo’’
- (Con estos dos medios hicimos lo mismo que con el primero: Calentamos
y metimos en las placas de Petri)
Las dejamos enfriar y más tarde las metimos en la nevera, para
luego poder cultivar nuestro hongo en ellas. |
|
- Cuando hirvió, lo retiramos del calentador y lo echamos en
una placa de Petri, cerca de una bombona encendida para evitar contaminaciones.
- Esta preparación la marcamos con ‘’L-repilo’’
para saber que es nuestra placa y que es el medio líquido.
|
|
| r4 |
|
| Comenzamos raspando el haz de una hoja sobre la placa de agar |
|
| |
|
| |
|
| |
|
| 
Imagen obtenida de una publicación
Ver
trabajo original. |
|
| |
|
| |
|
| Verticilosis
|
| Fuentes de información: |
|
| v1 |
|
| v2 |
|
| v3 |
|
| v4 |
|
| |
|
| |
|
| |
|
Adaptación para la actividad
del stand.
1ª
Un juego que es la ruleta sobre enfermedades causadas por hongos.
|
 |
2ª
Muestras de hojas infectadas y sanas para que vean y puedan comparar
la diferencia entre ellas
|
 |
3ª
Placas de petri en las cuales hemos plantado al hongo.
|
|
4ª
Porta objetos para que nuestros visitantes puedan ver y entender mejor
como es este tipo de hongo
|
 |